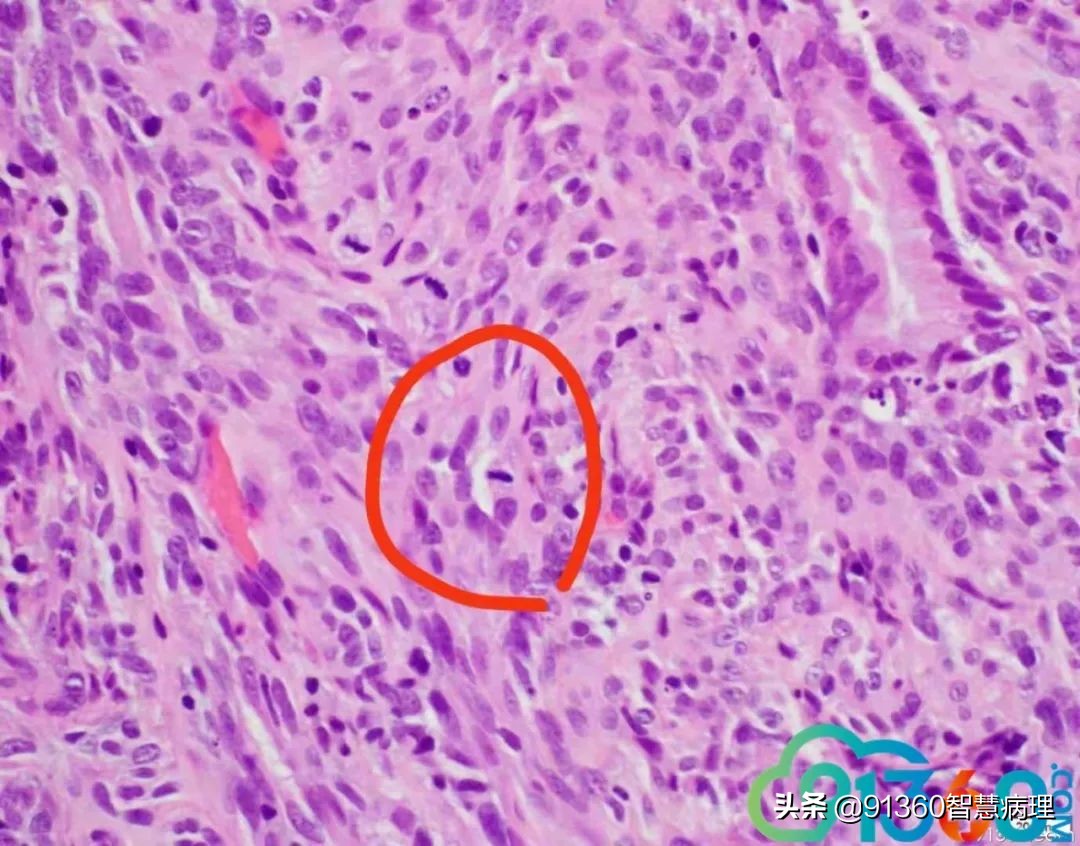
宫颈腺癌silvaa型用化疗吗,宫颈腺癌silvab型需要放疗几次

邢德印 39岁,宫颈活检 石岩 腺肉? 任永昌 梭形细胞恶性肿瘤,肉瘤首考,肉瘤样癌次之! 郭晓静 @邢德印(妇科病理)邢老师, 周末好!您的病例肯定有难度谢谢分享!抛砖引玉,我说下自己看法。1.39岁,为什么要活检?hpv情况和液基肯定有问题2.低倍这一点给我的感觉是有异型,其他很多似乎很弥漫,没有找到鳞状上皮,梭形细胞样

郭晓静 3.粘液上皮并没有小叶状结构,分散零散,最左边也就是放大倍数的 我感觉是有异型性的4.所以,是鳞的病变还是腺的病变,还是合并?还是梭形细胞间叶源性的病变~~我没有把握 但腺肉瘤的话,我感觉是不是要看到低倍的袖套样结构呢? 期待老师讲解!谢谢分享!

邢德印 @石岩 临颍人民 @临沂市中心医院任永昌 @深圳市人民医院病理科郭晓静 @临沂市中心医院任永昌 任院长发言一如既往的靠谱AE1/AE3、Cam5.2、P16、High risk HPV 混合、 HPV18





邢德印 Desmin -Sarcomatoid carcinoma; spindle cell carcinoma 石岩 @邢德印(妇科病理) 好例子 邢德印 以前没见过这么明显的,太肉瘤样了 任永昌 @邢德印(妇科病理) 赞 郭晓静 @邢德印(妇科病理) 我偏向猜的答案也是这个,。谢谢分享! 王昀 @邢德印(妇科病理) 好例子,没见过这么弥漫肉瘤样的,回过头来看,好像还是有点结构的样子
邢德印 @王昀 301 圈里的是mitosis 任永昌 @邢德印(妇科病理) @王昀 301 实际上,上边这个腺体有异型,核过于大。
王昀 哦,我说那个裂隙,有点像腺的结构 邢德印 @临沂市中心医院任永昌 @王昀 301 腺体其实是entrapped,正常的腺体 王昀 我是想起乳腺的化生性癌,所以想看看有没有腺和梭形细胞过渡移行的地方,能找点线索,可能是知道答案后开始想象了,这个可能是假腺